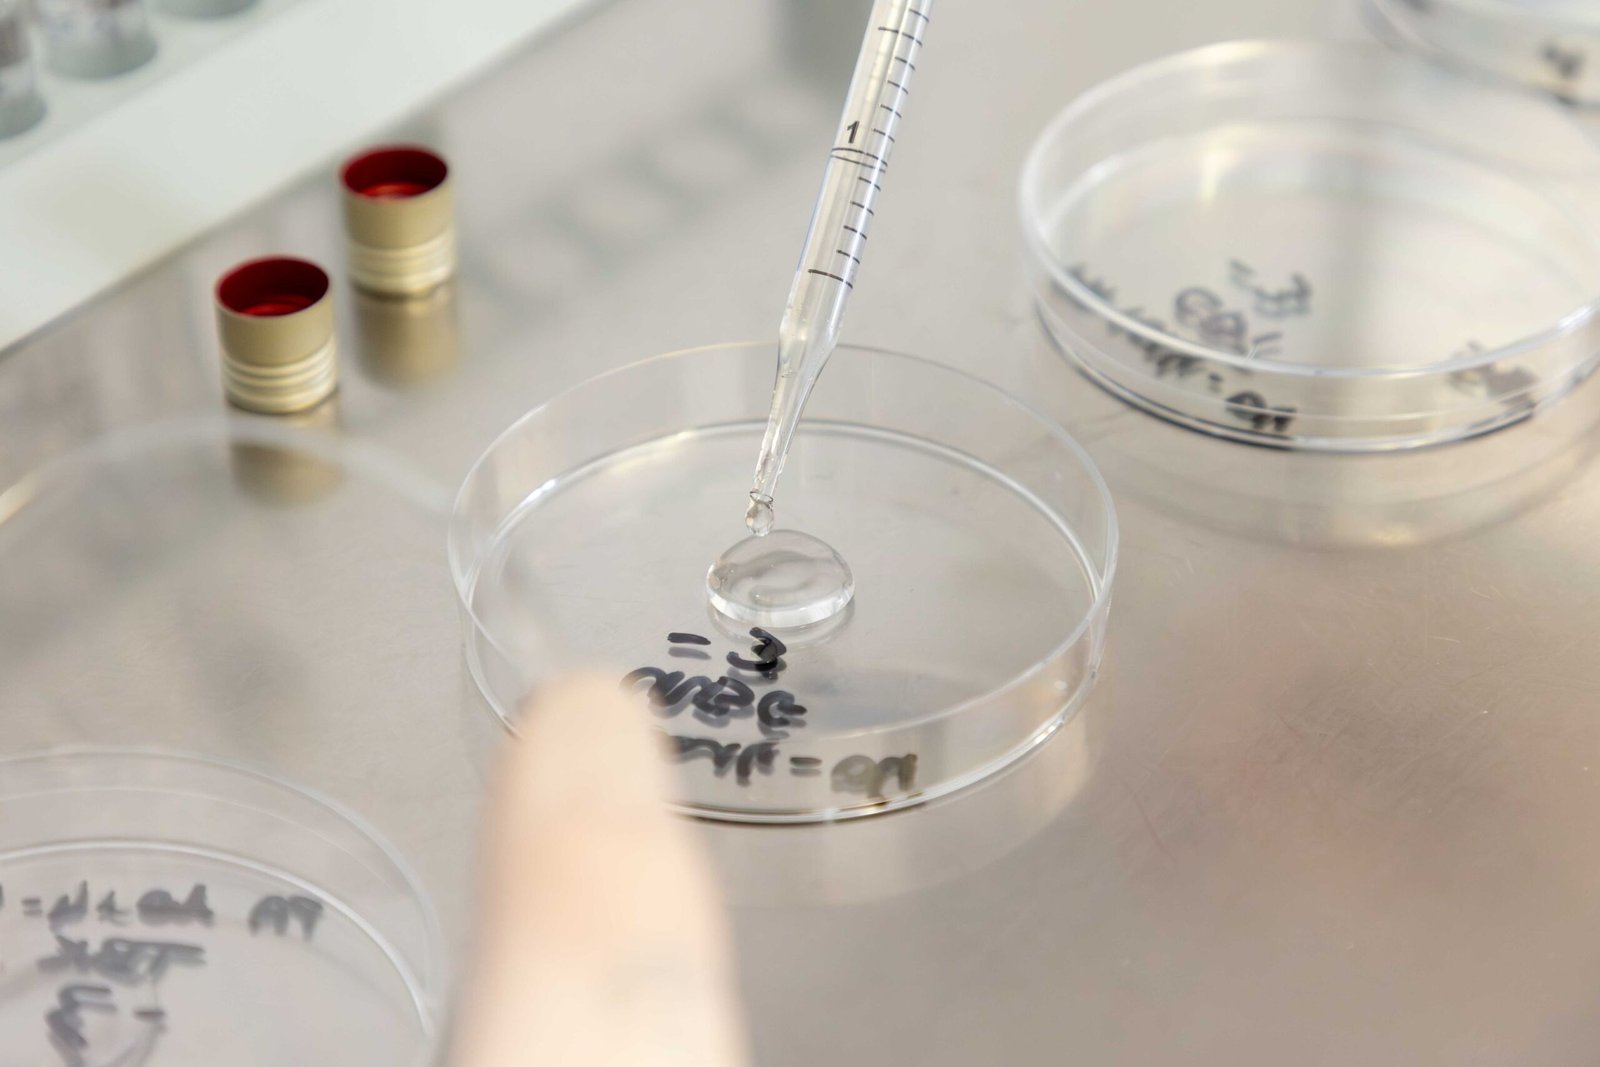

Soluzioni analitiche certificate per l'ambiente e l'industria
Laboratorio accreditato a Cremona per analisi ambientali in tutto il Nord Italia.
Garantiamo l'eccellenza della qualità attraverso test certificati
LAC esegue analisi chimiche e microbiologiche accreditate per supportare la tutela dell’ambiente, il monitoraggio dei processi industriali e la sicurezza dei prodotti. Grazie a tecnologie avanzate e metodi certificati, il laboratorio garantisce dati accurati, affidabili e completamente tracciabili. Supportiamo aziende e professionisti con competenze tecniche, test orientati alla conformità normativa e un supporto costante in ogni fase del processo analitico.
L'accuratezza scientifica come standard operativo
Dotato di strumentazione avanzata e accreditato ISO/IEC 17025, LAC garantisce elevati standard qualitativi in ogni fase del processo analitico. Forniamo dati affidabili, tracciabili e conformi, per supportare le decisioni tecniche di aziende, istituzioni e professionisti.
I nostri numeri
Oltre 35 anni di esperienza scientifica, con dati e volumi in costante crescita che confermano la fiducia che molti ci rinnovano ogni anno.